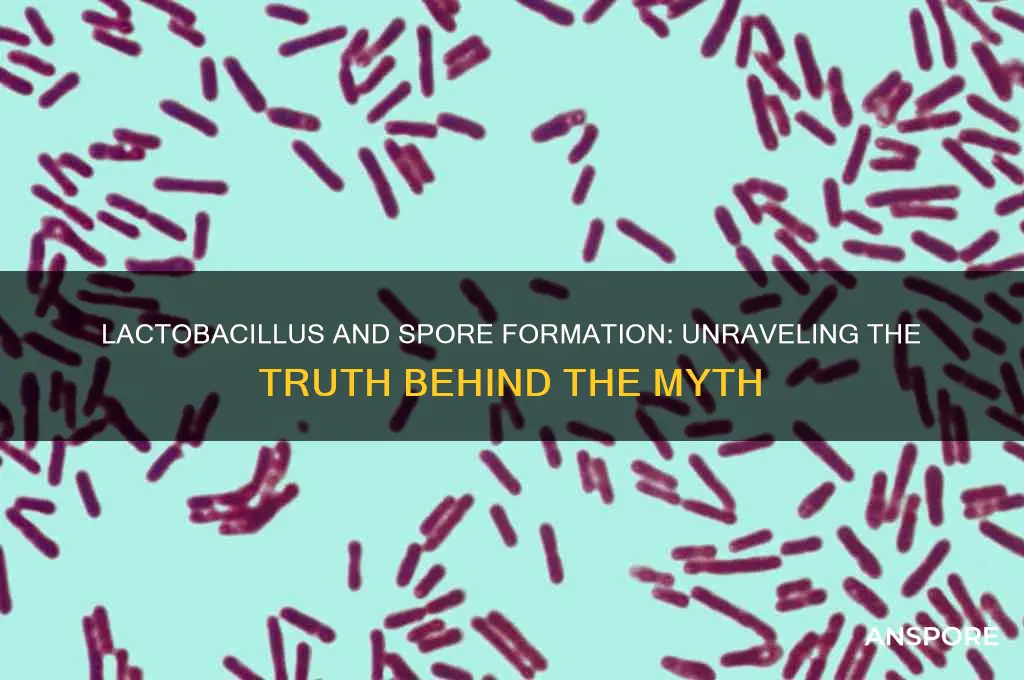
is lactobacillus spore forming

Lactobacillus, a genus of Gram-positive, rod-shaped bacteria, is widely recognized for its role in fermentation and its presence in the human gut microbiome. While many species of Lactobacillus are known for their probiotic benefits, a common question arises regarding their ability to form spores. Unlike spore-forming bacteria such as Bacillus or Clostridium, Lactobacillus species are generally non-spore-forming. This characteristic is significant because spore formation is a survival mechanism that allows bacteria to withstand harsh environmental conditions, such as high temperatures or desiccation. The absence of spore formation in Lactobacillus means that these bacteria rely on other mechanisms, such as acid tolerance and biofilm formation, to survive and thrive in their respective habitats. Understanding this distinction is crucial for applications in food science, probiotics, and microbial research, as it influences how Lactobacillus is handled, stored, and utilized in various industries.
| Characteristics | Values |
|---|---|
| Spore Formation | No, Lactobacillus is non-spore-forming. It belongs to the group of Gram-positive, facultative anaerobic or microaerophilic bacteria. |
| Shape | Rod-shaped (bacilli) |
| Gram Staining | Gram-positive |
| Oxygen Tolerance | Facultative anaerobic or microaerophilic |
| Habitat | Primarily found in the gastrointestinal tract, oral cavity, and vaginal tract of humans and animals |
| Metabolism | Fermentative, producing lactic acid as a major end product |
| Importance | Plays a crucial role in maintaining gut health, food fermentation (e.g., yogurt, cheese), and as a probiotic |
| Pathogenicity | Generally considered non-pathogenic; some strains are beneficial, while a few may cause infections in immunocompromised individuals |
| Antibiotic Sensitivity | Sensitive to certain antibiotics, but resistance can develop |
| Reproduction | Reproduces by binary fission |
| Cell Wall | Contains peptidoglycan and teichoic acids, typical of Gram-positive bacteria |
What You'll Learn
- Lactobacillus Species Overview: Not all Lactobacillus strains are spore-forming; most are non-spore-forming lactic acid bacteria
- Spore-Forming vs. Non-Spore-Forming: Spore-forming bacteria survive harsh conditions; Lactobacillus generally lacks this ability
- Exceptions in Lactobacillus: Some strains like *Lactobacillus sporogenes* (now *Bacillus coagulans*) were reclassified as spore-forming
- Survival Mechanisms: Lactobacillus relies on stress tolerance, not spores, for survival in adverse environments
- Industrial Applications: Non-spore-forming Lactobacillus is widely used in probiotics and fermentation processes

Lactobacillus Species Overview: Not all Lactobacillus strains are spore-forming; most are non-spore-forming lactic acid bacteria
Lactobacillus, a genus of gram-positive bacteria, plays a pivotal role in human health, particularly in gut and vaginal microbiota. While the term "spore-forming" often conjures images of resilience and survival, it’s critical to clarify that most Lactobacillus strains are non-spore-forming. This distinction is crucial for understanding their behavior in probiotics, fermentation, and clinical applications. Unlike spore-forming bacteria such as *Bacillus subtilis*, which can withstand harsh conditions like heat and acidity, non-spore-forming Lactobacillus strains rely on their ability to produce lactic acid for survival and function. This characteristic makes them highly effective in maintaining microbial balance but also limits their shelf stability and tolerance to environmental stressors.
From a practical standpoint, knowing whether a Lactobacillus strain is spore-forming or not directly impacts its use in supplements and food products. Non-spore-forming Lactobacillus strains, such as *Lactobacillus acidophilus* and *Lactobacillus rhamnosus*, are commonly found in probiotics and fermented foods like yogurt and kefir. However, their viability can be compromised during manufacturing, storage, or passage through the gastrointestinal tract. For instance, probiotic supplements often require refrigeration to maintain potency, and consumers are advised to take doses ranging from 1 to 10 billion CFUs (colony-forming units) daily, depending on age and health goals. In contrast, spore-forming bacteria, though not typical in the Lactobacillus genus, offer greater stability but may not provide the same metabolic benefits in the gut.
A comparative analysis reveals why non-spore-forming Lactobacillus strains dominate probiotic formulations despite their fragility. These strains excel in producing lactic acid, which lowers pH levels, inhibits pathogens, and supports immune function. For example, *Lactobacillus casei* has been shown to reduce the duration of diarrhea in children when administered at 5–10 billion CFUs daily. Spore-forming bacteria, while robust, often lack this acid-producing capability, making them less effective in modulating gut microbiota. This trade-off highlights the importance of selecting the right strain for specific health outcomes, rather than prioritizing spore-forming properties alone.
For those incorporating Lactobacillus into their health regimen, understanding strain-specific characteristics is key. Non-spore-forming strains are ideal for individuals seeking to enhance gut health, improve digestion, or prevent antibiotic-associated diarrhea. However, they require careful handling—store supplements in a cool, dry place, and consume fermented foods within their expiration dates. Pregnant women, infants, and immunocompromised individuals should consult healthcare providers before starting probiotics, as strain selection and dosage can vary. While spore-forming bacteria may offer advantages in certain contexts, the non-spore-forming nature of most Lactobacillus strains remains their defining strength in promoting microbial harmony.
In conclusion, the non-spore-forming nature of most Lactobacillus strains is not a limitation but a feature that aligns with their ecological role and therapeutic potential. By focusing on their lactic acid production and metabolic activities, these bacteria offer targeted benefits that spore-forming organisms cannot replicate. Whether in probiotics or fermented foods, the effectiveness of Lactobacillus lies in its ability to thrive in specific environments, not in surviving extreme conditions. This nuanced understanding empowers consumers and practitioners to make informed choices, ensuring optimal health outcomes through precise strain selection and application.
Are Magic Mushroom Spores Legal in the UK? Exploring the Law
You may want to see also

Spore-Forming vs. Non-Spore-Forming: Spore-forming bacteria survive harsh conditions; Lactobacillus generally lacks this ability
Bacteria have evolved diverse survival strategies, and one of the most remarkable is spore formation. Spore-forming bacteria, such as *Bacillus* and *Clostridium*, can withstand extreme conditions—heat, desiccation, radiation, and chemicals—by entering a dormant, highly resistant state. This ability hinges on the formation of a thick, protective spore coat and the reduction of metabolic activity to near zero. In contrast, non-spore-forming bacteria like *Lactobacillus* lack this mechanism, making them more vulnerable to environmental stressors. Understanding this distinction is crucial for applications in probiotics, food preservation, and industrial processes, where survival under harsh conditions can determine efficacy.
Consider the practical implications for probiotic supplementation. Spore-forming bacteria, such as *Bacillus coagulans*, are often marketed for their resilience, surviving stomach acid and antibiotics to reach the gut intact. A typical dose of spore-based probiotics ranges from 1 billion to 5 billion CFUs (colony-forming units) daily, depending on age and health status. Non-spore-forming *Lactobacillus* strains, however, require enteric coatings or encapsulation to protect them during transit. For instance, a standard dose of *Lactobacillus rhamnosus* GG is 10–20 billion CFUs, but without protective measures, viability drops significantly. This highlights the trade-off between natural hardiness and the need for technological intervention.
From a food preservation perspective, the absence of spore formation in *Lactobacillus* is both a challenge and an opportunity. Fermented foods like yogurt and sauerkraut rely on *Lactobacillus* to produce lactic acid, which inhibits pathogens. However, these bacteria are sensitive to heat and pH shifts, necessitating careful handling. For example, pasteurization at 72°C for 15 seconds can kill *Lactobacillus*, while spore-forming contaminants like *Bacillus cereus* may survive. To mitigate this, manufacturers often use starter cultures with high viability and controlled fermentation conditions. In contrast, spore-forming bacteria are targeted in canning processes, where temperatures exceeding 121°C are required to ensure safety.
The industrial use of bacteria further underscores the importance of spore formation. In wastewater treatment, non-spore-forming *Lactobacillus* strains are employed for their ability to degrade organic matter under specific conditions. However, their sensitivity limits their use in fluctuating environments. Spore-forming bacteria, on the other hand, are favored in bioremediation projects, where they can remain dormant until conditions become favorable. For instance, *Bacillus subtilis* spores are used to clean up oil spills, activating only when nutrients are available. This adaptability makes spore-forming bacteria indispensable in unpredictable settings.
In summary, the distinction between spore-forming and non-spore-forming bacteria like *Lactobacillus* has profound implications across health, food, and industry. While *Lactobacillus* excels in controlled environments, its lack of spore formation necessitates protective strategies. Spore-forming bacteria, with their innate resilience, offer advantages in harsh or variable conditions. Whether selecting a probiotic, preserving food, or designing industrial processes, understanding this difference ensures optimal outcomes. Practical tips include choosing spore-based probiotics for antibiotic users and ensuring proper storage of *Lactobacillus*-rich foods to maintain viability.
Buying Psychedelic Mushroom Spores: Legal or Illegal? What You Need to Know
You may want to see also

Exceptions in Lactobacillus: Some strains like *Lactobacillus sporogenes* (now *Bacillus coagulans*) were reclassified as spore-forming
Lactobacilli are widely recognized as non-spore-forming bacteria, a characteristic that has long defined their classification and applications in probiotics and fermentation. However, the story of *Lactobacillus sporogenes* challenges this generalization. Originally classified as a lactobacillus due to its lactic acid production, this strain was later reclassified as *Bacillus coagulans* after genetic analysis revealed its ability to form spores—a trait absent in true lactobacilli. This reclassification highlights the importance of genetic precision in microbiology and serves as a cautionary tale for assuming uniformity within bacterial genera.
The reclassification of *Lactobacillus sporogenes* to *Bacillus coagulans* was driven by advancements in DNA sequencing technology. While *B. coagulans* shares some metabolic properties with lactobacilli, such as producing lactic acid, its spore-forming capability aligns it more closely with bacilli. These spores are highly resilient, surviving extreme temperatures, pH levels, and desiccation, which makes *B. coagulans* particularly useful in industrial applications and as a probiotic. For instance, it is often included in shelf-stable probiotic supplements, where its spores can withstand manufacturing processes and stomach acidity to colonize the gut effectively.
From a practical standpoint, understanding this exception is crucial for consumers and healthcare providers. Probiotic products containing *B. coagulans* are marketed for their stability and ability to support digestive health, particularly in individuals with conditions like irritable bowel syndrome (IBS) or antibiotic-associated diarrhea. Dosage recommendations typically range from 1 billion to 3 billion CFUs (colony-forming units) daily for adults, though specific needs may vary based on age, health status, and the severity of symptoms. Always consult a healthcare professional before starting any new supplement regimen, especially for children, pregnant women, or those with compromised immune systems.
Comparatively, non-spore-forming lactobacilli, such as *Lactobacillus acidophilus* or *Lactobacillus rhamnosus*, require more careful handling and storage to maintain viability. They are often found in refrigerated probiotics and are sensitive to heat and moisture. In contrast, *B. coagulans*’ spore-forming ability allows it to remain potent without refrigeration, making it a convenient option for travel or regions with limited access to cold storage. This distinction underscores the importance of reading product labels and understanding the specific strains included in probiotic formulations.
In conclusion, while lactobacilli are generally non-spore-forming, the case of *Lactobacillus sporogenes* (now *Bacillus coagulans*) serves as a notable exception. Its reclassification not only clarifies its taxonomic position but also expands its utility in both industrial and health-related applications. By recognizing this exception, consumers and professionals can make more informed decisions about probiotic use, ensuring the right strain is selected for the intended purpose. Whether for gut health, food preservation, or other applications, the unique properties of *B. coagulans* make it a valuable outlier in the world of probiotics.
Airborne Spores' Water Survival: Unveiling Their Aquatic Resilience Secrets
You may want to see also

Survival Mechanisms: Lactobacillus relies on stress tolerance, not spores, for survival in adverse environments
Lactobacillus, a genus of lactic acid bacteria, is renowned for its role in fermentation and probiotic benefits. Unlike some bacteria, Lactobacillus does not form spores, a common survival strategy in harsh conditions. Instead, it relies on stress tolerance mechanisms to endure adverse environments. This distinction is crucial for understanding its behavior in food products, the gut microbiome, and industrial applications.
Analytical Perspective:
Lactobacillus employs a suite of stress tolerance mechanisms to survive challenges like low pH, high salt concentrations, and temperature fluctuations. For instance, it produces stress proteins, such as heat shock proteins, to maintain cellular integrity under heat stress. Additionally, it accumulates compatible solutes like trehalose to protect its membranes in osmotic stress. These adaptations allow Lactobacillus to thrive in environments like yogurt, where pH levels can drop below 4.5, or in the gastrointestinal tract, where bile salts pose a significant threat. Unlike spore-forming bacteria, which encapsulate their DNA in a dormant, protective state, Lactobacillus remains metabolically active, leveraging its robust stress response systems to persist.
Instructive Approach:
To maximize the survival of Lactobacillus in adverse conditions, consider these practical tips. In food production, maintain a controlled fermentation environment with optimal pH (around 5.0–6.5) and temperature (30–40°C) to minimize stress. For probiotic supplements, choose products with enteric coatings to protect the bacteria from stomach acid. When storing Lactobacillus-containing products, refrigerate them to slow metabolic activity and reduce stress-induced damage. For industrial applications, pre-adapt Lactobacillus cultures to sublethal stress conditions, such as gradual exposure to low pH, to enhance their tolerance. These strategies ensure the bacteria remain viable and functional, even in challenging settings.
Comparative Insight:
While spore-forming bacteria like Bacillus subtilis can survive extreme conditions by entering a dormant state, Lactobacillus’s approach is fundamentally different. Its stress tolerance mechanisms allow it to remain active and responsive, which is particularly advantageous in dynamic environments like the human gut. For example, Lactobacillus’s ability to produce exopolysaccharides helps it adhere to intestinal walls, enhancing its survival in the presence of bile acids. In contrast, spore-forming bacteria must germinate to become metabolically active, a process that can be less efficient in rapidly changing environments. This active survival strategy makes Lactobacillus a key player in maintaining gut health and fermenting foods, despite its lack of spore formation.
Descriptive Takeaway:
Imagine Lactobacillus as a resilient explorer navigating a hostile landscape, armed not with a shelter but with a toolkit of adaptive strategies. Its stress tolerance mechanisms—from molecular chaperones to osmoprotectants—enable it to withstand the rigors of acidic environments, high salt concentrations, and oxidative stress. This active resilience is what makes Lactobacillus indispensable in probiotics, fermented foods, and biotechnology. By understanding and supporting these mechanisms, we can harness its full potential, ensuring its survival and efficacy in diverse applications. Unlike spore-forming bacteria, Lactobacillus thrives through persistence, not dormancy, making it a unique and vital organism in both natural and industrial ecosystems.
Effective Methods for Treating Spores: A Comprehensive Guide
You may want to see also

Industrial Applications: Non-spore-forming Lactobacillus is widely used in probiotics and fermentation processes
Lactobacillus, a genus of lactic acid bacteria, is predominantly non-spore-forming, which distinguishes it from spore-forming bacteria like Bacillus. This characteristic, while limiting its survival in extreme conditions, makes non-spore-forming Lactobacillus uniquely suited for specific industrial applications, particularly in probiotics and fermentation processes. Its inability to form spores ensures consistent metabolic activity, a critical factor in controlled environments where predictability is key.
In the realm of probiotics, non-spore-forming Lactobacillus strains, such as *Lactobacillus rhamnosus* GG and *Lactobacillus casei*, are widely incorporated into dietary supplements, yogurts, and beverages. These strains are selected for their ability to transiently colonize the gut, modulate the microbiome, and enhance immune function. For instance, a daily dose of 1–10 billion CFU (colony-forming units) is commonly recommended for adults to maintain gut health. Unlike spore-forming bacteria, which can remain dormant until conditions are favorable, non-spore-forming Lactobacillus requires careful handling to ensure viability during manufacturing and storage. Manufacturers often use protective packaging, such as blister packs or refrigerated storage, to preserve efficacy.
Fermentation processes in the food industry heavily rely on non-spore-forming Lactobacillus for its role in producing lactic acid, which acts as a natural preservative and flavor enhancer. In dairy fermentation, strains like *Lactobacillus delbrueckii* subsp. *bulgaricus* and *Lactobacillus helveticus* are essential for producing yogurt, cheese, and kefir. These bacteria convert lactose into lactic acid, reducing pH and inhibiting pathogenic growth. Similarly, in vegetable fermentation, *Lactobacillus plantarum* is used to produce sauerkraut, kimchi, and pickles. The non-spore-forming nature of these bacteria ensures continuous fermentation activity, as they remain metabolically active throughout the process, unlike spore-forming bacteria that might delay fermentation onset.
Despite their widespread use, non-spore-forming Lactobacillus strains present challenges in industrial settings. Their sensitivity to heat, oxygen, and pH fluctuations necessitates precise control of fermentation conditions. For example, temperatures above 40°C can rapidly inactivate these bacteria, requiring cooled environments during production. Additionally, their inability to form spores means they are less resilient during distribution and storage, often requiring refrigeration or freeze-drying to extend shelf life. However, these challenges are outweighed by their advantages in producing consistent, high-quality fermented products and effective probiotics.
In summary, the non-spore-forming nature of Lactobacillus is not a limitation but a feature that aligns with its industrial applications. Its reliability in probiotics and fermentation processes stems from its continuous metabolic activity and predictable behavior. While careful handling is required, the benefits—such as enhanced gut health and superior food preservation—make non-spore-forming Lactobacillus indispensable in modern biotechnology and food production. Practical tips for optimizing its use include maintaining strict temperature control, using protective packaging, and adhering to recommended CFU dosages for probiotic formulations.
Airborne Mold Spores: Lifespan After Leaving the Source Explained
You may want to see also
Frequently asked questions
No, Lactobacillus is not a spore-forming bacterium. It belongs to the group of lactic acid bacteria and does not produce spores as a survival mechanism.
Lactobacillus lacks the genetic and physiological mechanisms required for spore formation, which are typically found in bacteria like Bacillus and Clostridium.
Lactobacillus relies on other survival strategies, such as producing lactic acid and tolerating acidic environments, rather than forming spores to withstand harsh conditions.
No, Lactobacillus is distinct from spore-forming probiotics like Bacillus coagulans, which do form spores as a protective measure.
No, the lack of spore formation does not diminish Lactobacillus's effectiveness as a probiotic. Its benefits are derived from its ability to colonize the gut and produce beneficial compounds, not from spore formation.

